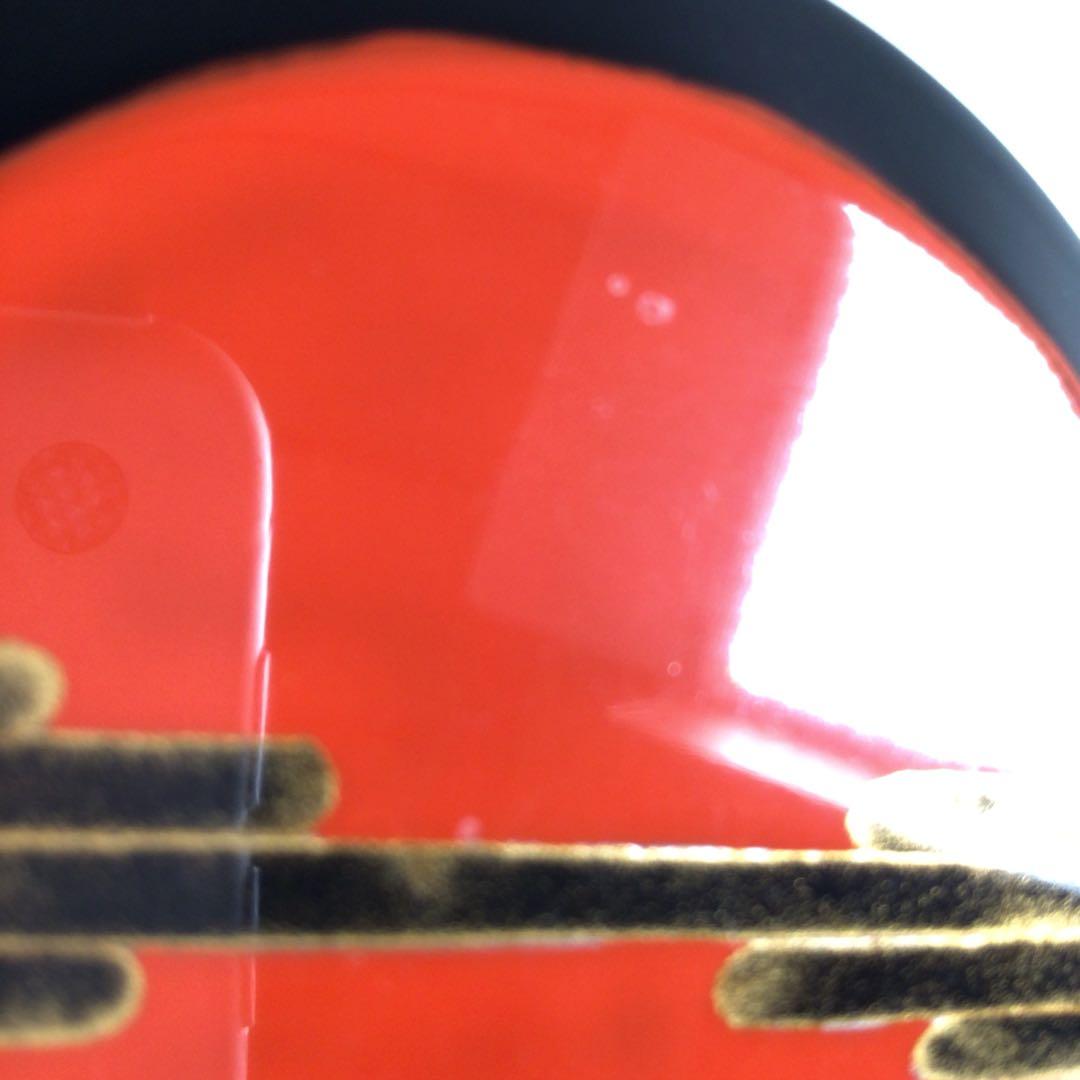
Ｒ３２９　棗　『前端春斎作』『草木蒔絵』『雪吹棗』　共箱　茶道具

マイストア
変更
お店で受け取る
(送料無料)
配送する
納期目安:
2026.03.13 22:58頃のお届け予定です。
決済方法が、クレジット、代金引換の場合に限ります。その他の決済方法の場合はこちらをご確認ください。
※土・日・祝日の注文の場合や在庫状況によって、商品のお届けにお時間をいただく場合がございます。
R329 棗 『前端春斎作』『草木蒔絵』『雪吹棗』 共箱 茶道具の詳細情報
高さ 約 ⒎5cm横幅 約 ⒍5cm※素人の測定のため、誤差がございます。薄い傷、汚れが少々ありますまだまだ、十分に使用できます。どうぞよろしくお願い致します。#煎茶道具#表千家#裏千家#茶道具#大徳寺#懐石道具#華道#花瓶#陶器#花入#骨董#鉄瓶#南部#陶芸#香道具#香道#七事式#花器#炭道具#灰道具#酒器#利休#時代#文房具#莨#喫煙具#茶釜#銀製#置物#掛軸#錫#銅製#鉄製#いぶし銀#木製#竹製#中国#漆塗#漆器#菓子器。【茶道具】白丹波 正元直作 茶入 【新品未使用】。江戸火鉢 関東火鉢 長火鉢 囲炉裏 角火鉢 五徳 火箸 引出し 手あぶり 茶道具。楽吉左衛門十四代 覚入 黒茶碗/裏千家十五世 鵬雲斎 書付 花押
ベストセラーランキングです
近くの売り場の商品
カスタマーレビュー
オススメ度 4.5点
現在、4445件のレビューが投稿されています。

![バトスピ [10thディーバプリマ] ディアナフルール シークレット 2枚](/qneh/nHR0cHZ6Ly9zdGF0aWZuoWVyY2RuYm5ldC9cdGVtL2EldGSpbC9vcmlnL3/Obb3Evcy9tNTA3OTA1MDI0MzAfMS5qcGc-.jpg)

![[最安値]リザードンex SAR psa10 SV2a ポケモンカード151](/qneh/nHR0cHZ6Ly9zdGF0aWZuoWVyY2RuYm5ldC9cdGVtL2EldGSpbC9vcmlnL3/Obb3Evcy9tMTk0OTY1MjIzNjEfMS5qcGc-.jpg)





